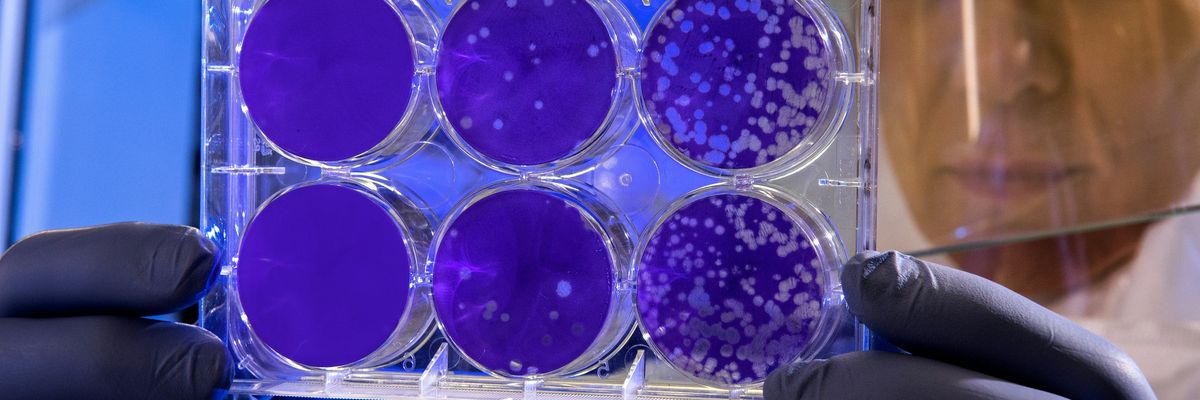

A new review published in Environmental Science and Ecotechnology evaluates photosynthetic microorganisms’ potential as tools for degrading microplastic pollution both on land and in aquatic ecosystems.
In short:
- Several microorganisms have demonstrated an ability to grow on the surface of various types of plastics and break them down through the use of sunlight and CO2.
- The advantages of using microorganisms include their low cost, low carbon footprint, and their amenability to genetic modifications.
- However, the authors point out the ethical concerns that come with using genetically modified organisms, as well as the potential for unintended consequences.
Key quote:
“Using these microorganisms may not be a complete solution to plastic pollution but rather a complementary approach that can be used in conjunction with other strategies.”
Why this matters:
Micro and nanoplastics pose a severe threat to ecosystems of all types, and the massive amount of plastic waste generated globally creates an urgent need for innovative solutions. In addition to the potential ethical and regulatory issues called out in this study, there’s concern that the biodegradation of plastics may release poorly-understood plastic chemicals into the environment, potentially causing more damage to human and wildlife health. While it’s important to further research alternative methods for managing existing plastic waste, it’s also critical to advocate for limits on plastic production to stop pollution at its source.
Related EHN coverage:
- Bioplastics: sustainable solution or distraction from the plastic waste crisis?
- Degrading plastic waste using the power of superworm guts
More resources:
Barone, Giovanni et al. for Environmental Science and Ecotechnology vol. 20. Jul. 2024
- Scientists are using bacteria to remove harmful contaminants from our water. Here's how. ›
- Combating carbon emissions with soil microbes ›